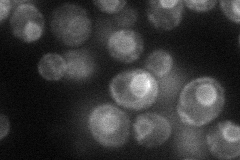
YBR296C
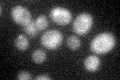
YBR296C
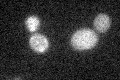
YBR296C

View description
Na+/Pi cotransporter, active in early growth phase; similar to phosphate transporters of Neurospora crassa; transcription regulated by inorganic phosphate concentrations and Pho4p
Localization:
Intensity:
Fold change:
Significance:
-
C’ GFP library in SD

below threshold15.04 -
N' NOP1pr-GFP in SD
ER39.1477 -
N' TEF2pr-mCherry in SD

ER15.0691 -
N' NATIVEpr-GFP in SD

below threshold17.3853 -
N' TEF2pr-VC and Cyto-VN in SD

below threshold25.1886 -
C’ GFP library in SD+DTT
cytosol14.510.96No -
C’ GFP library in SD+H2O2
cytosol16.261.08No -
C’ GFP library in Starvation Media

cytosol22.371.48No -
C’ GFP library on the background of Pup2-DaMP

N/A -
C’ GFP library on the background of CCT mutant

N/A0N/AYes
